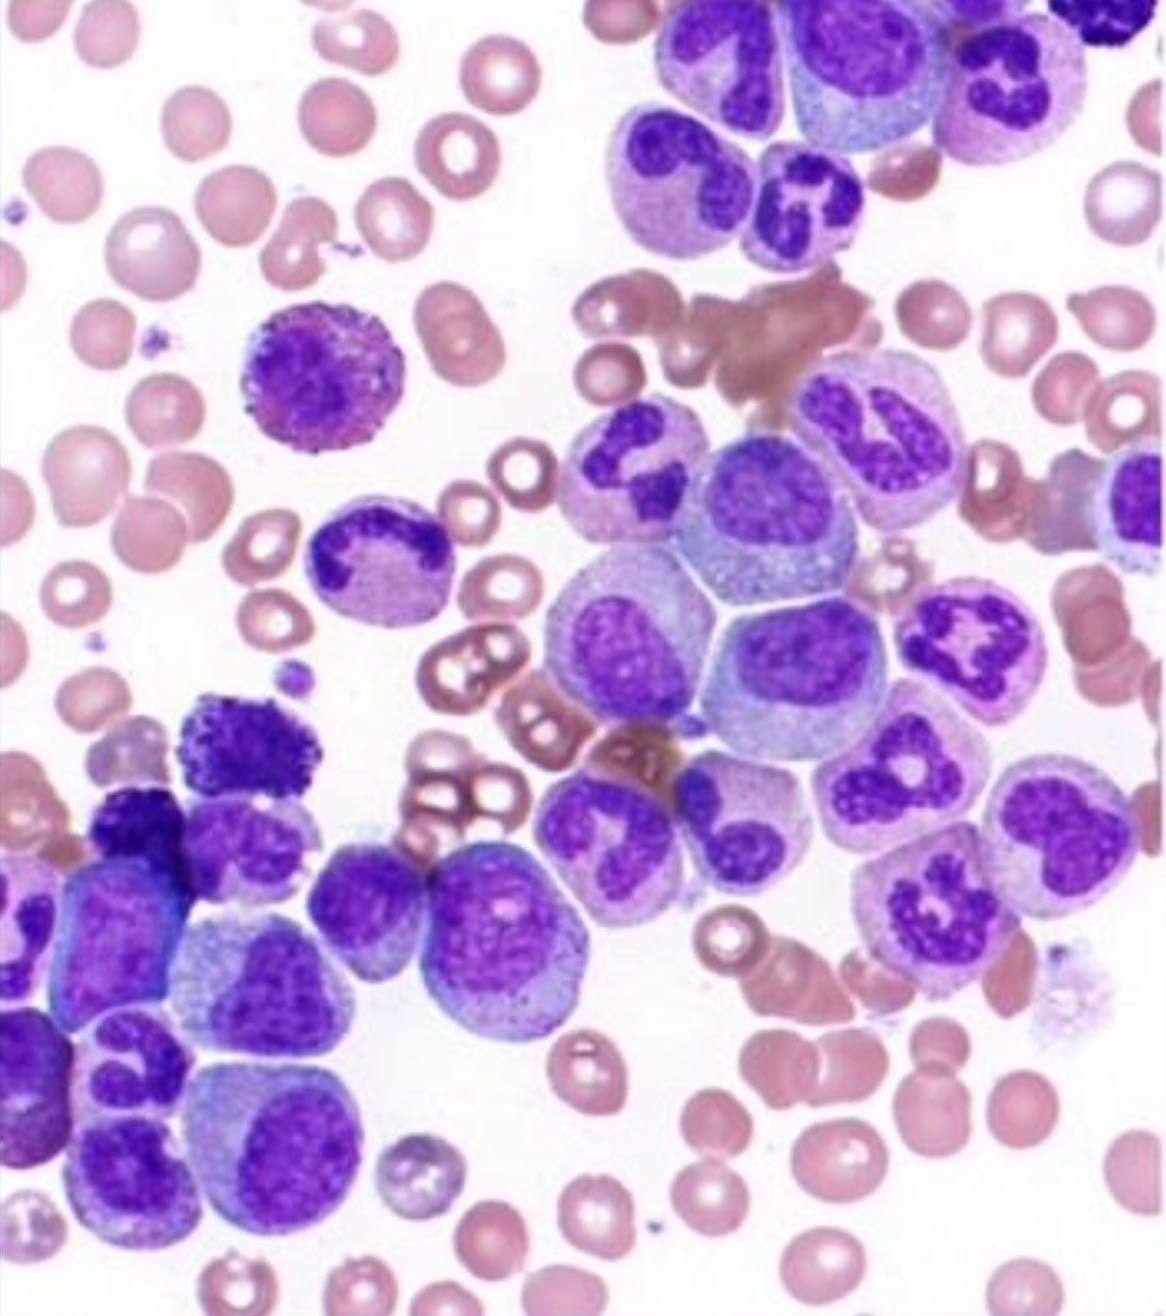
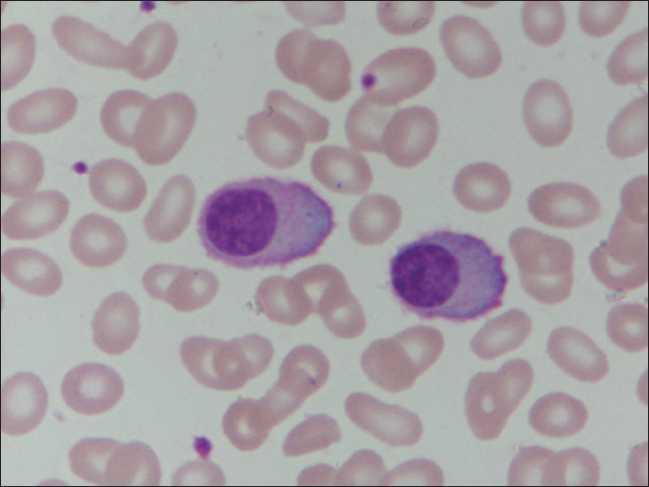

What disease does this blood film suggest?

- ALL
- Could also possibly be AML M0-1
What disease does the following immunophenotype suggest? Sig+, CD5+, Cyclin D1+, CD20+, CD10-, CD23-, BCL6-, MUM1-
- Mantle cell lymphoma
- (Aberrant CD5 and Cyclin D1 expression)
What disease does this blood film suggest?

CLL
- Lymphocytosis
- Smear cells
What is the treatment for APML?
ATRA and arsenic
What is the main genetic cause of Burkitt lymphoma?
-Lost regulation of c-myc
Outline clinical presentation of MDS
- Signs of bone marrow failure
- fatigue, infections, easy bruising
- Bone marrow hypercellular
- Cytopenia (a dysplastic change of a particular lineage causes the cytopenia of that lineage, i.e anaemia in erythroid dysplasia)
What disease does the following immunophenotype suggest? CD45+, CD13+, CD33+, CD117+, CD34+, HLA-DR+, CD19-, Tdt-
- AML M0/M1/M2
- CD34+, HLA-DR+, (Both markers of immaturity)
-What viruses can cause infectious mononucleosis?
EBV and CMV
What disease does this blood film show?
CML, in chronic phase
Myelocytes and basophils can be prewent
Outline the pathophysiology of CML
- Translocation occurs between chromosome 9 and 22, forming BCR-ABL1 fusion gene
- BCR-ABL1 molecule is a constitutively active tyrosine kinase
- Causes downstream activation of oncogenes, such as JAK, PI3K and RAS
- Leading to increased proliferation, survival and clonal expansion of cells with the initial t(9;22) mutation.
Outline the clinical presentation of Adult T-cell laeukaemia/lymphoma (ATL)
- Human T-cell lymphotrophic virus 1 (HTLV-1)
- Hypercalcaemia
- Skin rash
- Other things pertaining to ALL or NHL
How does Multiple myeloma lead to bone weakness?
- Multilpe myeloma (MM) cells overproduce RANK ligand
- Osteoprotegerin (OPG) is downregulated (MM endocytosis)
- Leads to activation of osteoclasts
- MM cels produce Dkk-1 which inhibit osteoblasts
- produces sclerostin, which inhibits osteoblasts
- Imbalance of osteoblast/osteoclast activity leads to osteolytic lesions and bone weakness
Case: A 51 year old woman was admitted to hospital showing: Asthenia(weakness), anorexia, weight loss. No significant findings on physical examination. Haemoglobin 83, WBC 6.5, platelets: 245. ESR 138 (high). IgA 14.1(high). Creatine 290 (high). See serum protein electrophoresis. CD38+, CD56+. What is the most likely diagnosis?

Multiple myeloma
Outline the causes of Marginal zone lymphoma
- Hep C
- H pylori
- Autoimmune causes
What disease does the following immunophenotype suggest? CD30+, CD15+, CD79a-, SmIg-, CD45-, CD34-, Tdt-
Hodgkin lymphoma
(CD30+, CD15+)
What disease oes this immunophenotype suggest?CD45-, no SCC, CD19-, CD33+, CD7-, CD13+
-AML M0-M1
What disease does this blood film suggest?
Multiple myeloma
-Characteristic, pushed off to one side, extended cytoplasm
What are the viruses that can contribute to lymphoma?
EBV (Burkitt, Hodgkin)
HIV (Hodgkin, High grade B-cell lymphoma)
HTLV-1 (ATLL)
Hep C (Marginal zone lymphoma)
Human Herpes Virus (HHV8)
Hep B
What are the most common cytogenetic abnormalities associated with ALL?
- High hyperdiploidy (good prognosis)
- t(12;21)/ETV6-RUNX1 (Childhood, Good prognosis)
- t(9;22)/BCR-ABL1/Ph (older adults, bad prognosis)
- 11q23 rearrangements/KMT2A (infants, bad prognosis)
- t(1;19)/TCF-PBX1
- T-ALL: t(10;14)
What is the mechanism of action of Imatinib?
- Imatinib is a tyrosine kinase inhibitor
- It binds to the ATP binding site of BCR-ABL1, preventing ATP from binding and donating it’s phosphate.
- Therefore no activation of oncogenic proteins
What disease does this blood film suggest?

Mantle cell lymphoma
-Characteristic morphology?
Outline the main subtypes of myelodysplastic syndrome
- Single lineage dysplasia
- Erythroid dysplasia
- Granulocytic dysplasia
- Megakaryocytic dysplasia
- Multiple lineage dysplasia
- Adult
- Childhood
- Ring Sideroblasts (Single lineage erythroid dysplasia)
- 5q deletion
- Excess blasts
- Excess blasts type 1 (5-9% blasts)
- Excess blasts type 2 (10-19% blasts)
What genes are involved in multiple myeloma?
- IGH gene can be fused with:
- Cyclin D1
- MMSET gene
- Maf
- All leading to overproduction of Ig? (I think lol)
Describe the myeloid maturation sequence
Myeloblast,
Promyelocyte,
Myelocyte,
Metamyelocyte,
Band,
granulocyte (e.g Neutrophil)





























